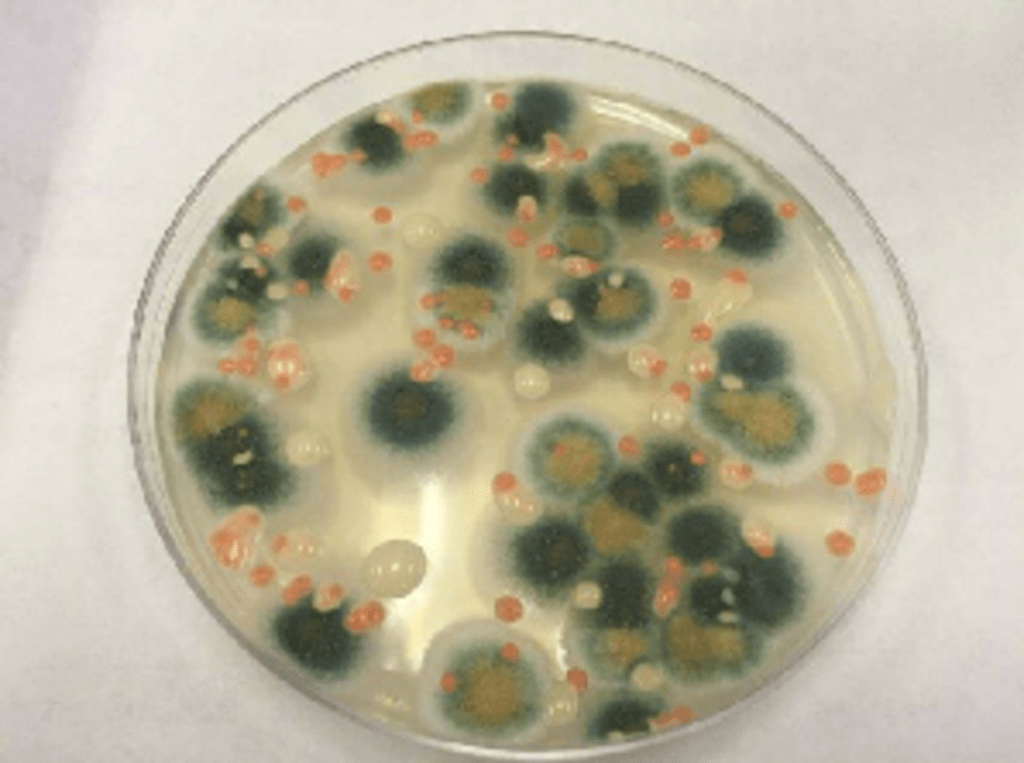
Hongo negro que crece dentro de Chernóbil se alimenta de la radiación gamma mortal

La explosión del reactor número 4 en la central nuclear de Chernóbil, ocurrida el 26 de abril de 1986, dejó tras de sí una de las zonas más contaminadas por radiación en la Tierra. Décadas después, los niveles de radiación siguen siendo letales para la mayoría de las formas de vida. Sin embargo, en este entorno extremo, los científicos descubrieron un organismo sorprendente: Cladosporium sphaerospermum, un hongo negro que parece no solo resistir la radiación, sino también «alimentarse» de ella. Este descubrimiento ha abierto nuevas posibilidades en el campo de la biotecnología, la biorremediación y la exploración espacial.
Un hongo negro que sobrevive con radiación

Después del desastre, investigadores encontraron manchas negras creciendo en las paredes del reactor dañado. Estos hongos no solo sobrevivían, sino que prosperaban en un entorno con niveles extremos de radiación. Investigaciones posteriores revelaron que su pigmento oscuro, la melanina, juega un papel clave en este fenómeno.
La melanina es común en muchos organismos y protege contra la radiación ultravioleta, pero en C. sphaerospermum cumple una función aún más sorprendente: absorbe la radiación ionizante y la convierte en energía utilizable. Este proceso, llamado radiosíntesis, se asemeja a la fotosíntesis en plantas, donde la luz solar es transformada en energía química.
Un estudio publicado en PLOS ONE en 2007 demostró que estos hongos crecen más rápido en entornos altamente radiactivos que en condiciones normales, lo que sugiere que la radiación actúa como un recurso energético para ellos.
El hallazgo de C. sphaerospermum en Chernóbil ha despertado el interés de los científicos en su posible uso en biorremediación, un proceso en el que organismos vivos ayudan a eliminar contaminantes del medio ambiente.
En sitios altamente radiactivos, como Fukushima o Chernóbil, la limpieza con métodos convencionales es peligrosa y costosa. En cambio, los hongos radiotróficos podrían absorber la radiación y contener su propagación de manera natural. Investigaciones publicadas en FEMS Microbiology Letters sugieren que ciertos hongos pueden ser usados para retener y degradar materiales radiactivos, ofreciendo una posible solución a la contaminación nuclear.
Exploración espacial: ¿Podría este hongo proteger a los astronautas?

Más allá de su impacto en la Tierra, C. sphaerospermum ha sido enviado a la Estación Espacial Internacional (ISS) para evaluar si su resistencia a la radiación puede ser aprovechada en futuras misiones espaciales.
Uno de los principales problemas para los viajes largos al espacio es la exposición a radiación cósmica, que puede dañar el ADN humano y aumentar el riesgo de enfermedades. Los estudios preliminares han indicado que este hongo podría absorber parte de esa radiación y actuar como un escudo natural, lo que sugiere que podría usarse para revestir hábitats en Marte o la Luna y proteger a los astronautas.
Además, su capacidad de crecer en entornos extremos lo hace un candidato para la producción de alimentos en el espacio, ya que podría servir como fuente de nutrientes en condiciones adversas.
El futuro de la investigación: Aplicaciones en biotecnología
La extraordinaria capacidad de C. sphaerospermum ha llevado a los científicos a explorar otras posibles aplicaciones:
- Desarrollo de materiales resistentes a la radiación, inspirados en la estructura de la melanina del hongo.
- Cultivos agrícolas adaptados a climas extremos, utilizando genes responsables de su resistencia.
- Nuevos enfoques en medicina, como la protección celular contra la radiación en pacientes sometidos a tratamientos como la radioterapia.
A medida que la investigación avanza, este pequeño hongo podría revolucionar la forma en que enfrentamos los desafíos ambientales y tecnológicos del futuro.
El descubrimiento de Cladosporium sphaerospermum en Chernóbil ha cambiado la forma en que entendemos la vida en condiciones extremas. Su capacidad de utilizar la radiación como fuente de energía no solo desafía las expectativas científicas, sino que también ofrece soluciones innovadoras en biotecnología, exploración espacial y limpieza de desechos nucleares.
Si este hongo ha encontrado la manera de sobrevivir y prosperar en el lugar más radiactivo de la Tierra, ¿qué otras posibilidades nos esperan en los rincones más inhóspitos del universo?
Referencia:
- PLOS One/Ionizing Radiation Changes the Electronic Properties of Melanin and Enhances the Growth of Melanized Fungi. Link.
- FEMS Microbiology Letters/Fungi and ionizing radiation from radionuclides. Link.
Relacionado
Descubre más desde Cerebro Digital
Suscríbete y recibe las últimas entradas en tu correo electrónico.
